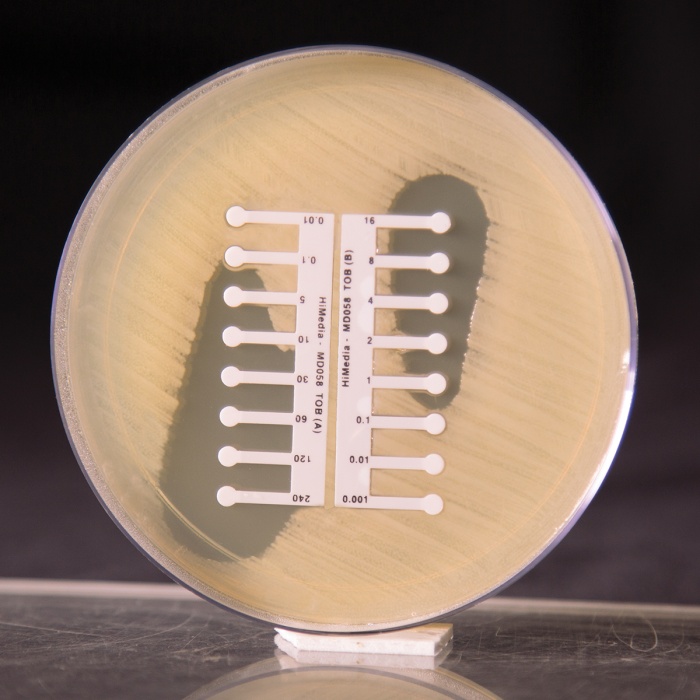
Tobramycin

Shop By
Shopping Options
- Price
-
—"To" value should be greater